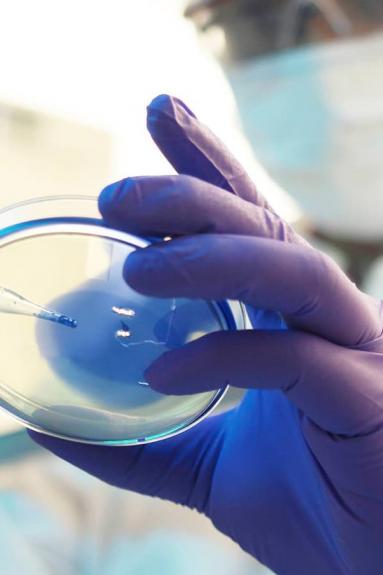

Diploma Universitario enBiotecnología
Asignaturas
- Módulo II: Bioética
Asignaturas
Datos personales
El responsable del tratamiento de los datos personales es la FUNDACIÓN UNIVERSITARIA SAN ANTONIO. Sus datos personales incluidos su número de teléfono móvil, serán tratados para la gestión de las actividades de información y asesoramiento, atención de su consulta y el envío de comunicaciones promocionales y de servicios vinculados a la Institución a través de los canales de información de la universidad incluido WhatsApp, email y teléfono.
La base legal del tratamiento es su consentimiento. Sus datos serán conservados de forma indefinida hasta que no solicite su cancelación. Puede ampliar la información sobre la Política de Privacidad en www.ucam.edu.
Puede contactar con el Delegado de Protección de datos en dpd@ucam.edu. Tiene derecho a acceder a esta información, rectificarla, cancelarla, y demás derechos recogidos en la LOPD y reglamento UE 2016/679 dirigiéndose a la Secretaría de la Universidad de forma presencial o por escrito acreditando su identificación en secretaria@ucam.edu.
Para más información puede visitar: https://www.ucam.edu/aviso-legal